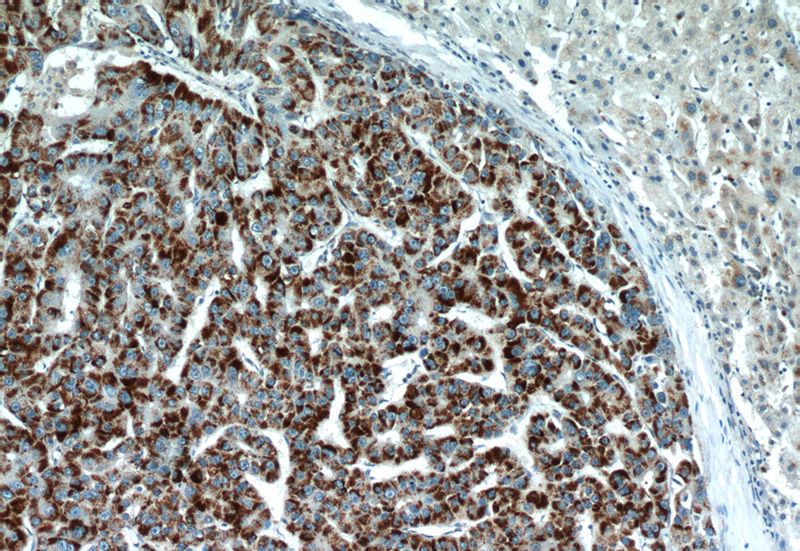
Immunohistochemical of paraffin-embedded human liver cancer using Catalog No:113727(PEX14 antibody) at dilution of 1:50 (under 10x lens)
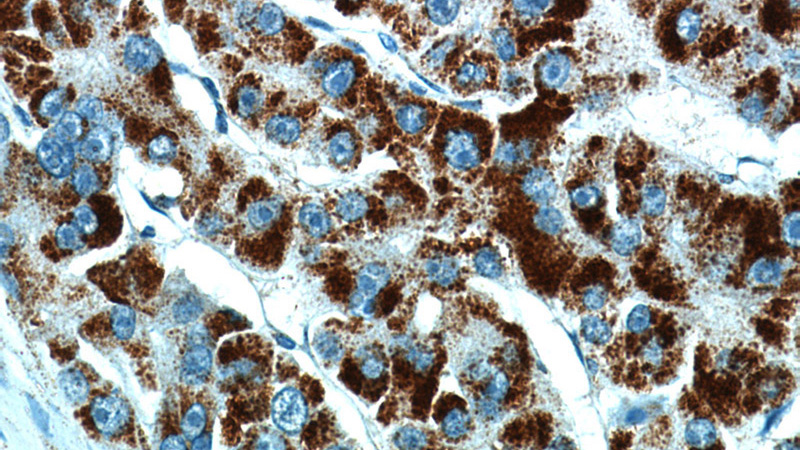
Immunohistochemical of paraffin-embedded human liver cancer using Catalog No:113727(PEX14 antibody) at dilution of 1:50 (under 40x lens)

-
Product Name
PEX14 antibody
- Documents
-
Description
PEX14 Rabbit Polyclonal antibody. Positive WB detected in human liver tissue. Positive IP detected in mouse liver tissue. Positive FC detected in HepG2 cells. Positive IF detected in HeLa cells, COS7 cells. Positive IHC detected in human liver cancer tissue, human cervical cancer tissue. Observed molecular weight by Western-blot: 57 kDa
-
Tested applications
ELISA, IF, WB, IP, IHC, FC
-
Species reactivity
Human,Mouse,Rat; other species not tested.
-
Alternative names
dJ734G22.2 antibody; NAPP2 antibody; Peroxin 14 antibody; PEX14 antibody; Pex14p antibody; PTS1 receptor dOCking protein antibody
-
Isotype
Rabbit IgG
-
Preparation
This antibody was obtained by immunization of PEX14 recombinant protein (Accession Number: NM_004565). Purification method: Antigen affinity purified.
-
Clonality
Polyclonal
-
Formulation
PBS with 0.1% sodium azide and 50% glycerol pH 7.3.
-
Storage instructions
Store at -20℃. DO NOT ALIQUOT
-
Applications
Recommended Dilution:
WB: 1:200-1:1000
IP: 1:200-1:2000
IHC: 1:20-1:200
IF: 1:20-1:200
-
Validations

human liver tissue were subjected to SDS PAGE followed by western blot with Catalog No:113727(PEX14 antibody) at dilution of 1:500

The antibody Catalog No:113727 stain the Peroxisomes of the COS7 cell transfected with YFP-Lpx1. IF result in Paper with PMID:21741480, Dr. Sven Thoms.

IF result of anti-PEX14 (Catalog No:113727) in Hela cell by Dr. Sven Thoms. Peroxisome Red,Nuclear Blue.
Immunohistochemical of paraffin-embedded human liver cancer using Catalog No:113727(PEX14 antibody) at dilution of 1:50 (under 10x lens)
Immunohistochemical of paraffin-embedded human liver cancer using Catalog No:113727(PEX14 antibody) at dilution of 1:50 (under 40x lens)

IP Result of anti-PEX14 (IP:Catalog No:113727, 3ug; Detection:Catalog No:113727 1:500) with mouse liver tissue lysate 4000ug.

1X10^6 HepG2 cells were stained with .2ug PEX14 antibody (Catalog No:113727, red) and control antibody (blue). Fixed with 4% PFA blocked with 3% BSA (30 min). Alexa Fluor 488-congugated AffiniPure Goat Anti-Rabbit IgG(H+L) with dilution 1:1500.
-
Background
PEX14 (peroxisomal biogenesis factor 14) is a peroxisomal membrane protein that is essential for protein docking onto the peroxisomes. It is a central component of the peroxisimal matrix protein import machinery and interacts with PEX5 and PEX19. PEX14 is ubiquitously expressed and defects in PEX14 are the cause of peroxisome biogenesis disorder complementation group K (PBD-CGK). This antibody can be used to detect endogenous PEX14 with an apparent molecular weight of 57 kDa (PMID: 16449325; 9653144) and recognize peroxisomal structures in human, monkey and mouse cells.
-
References
- Grønborg S, Krätzner R, Spiegler J. Typical cMRI pattern as diagnostic clue for D-bifunctional protein deficiency without apparent biochemical abnormalities in plasma. American journal of medical genetics. Part A. 152A(11):2845-9. 2010.
- Thoms S, Hofhuis J, Thöing C, Gärtner J, Niemann HH. The unusual extended C-terminal helix of the peroxisomal α/β-hydrolase Lpx1 is involved in dimer contacts but dispensable for dimerization. Journal of structural biology. 175(3):362-71. 2011.
- Kovacs WJ, Charles KN, Walter KM. Peroxisome deficiency-induced ER stress and SREBP-2 pathway activation in the liver of newborn PEX2 knock-out mice. Biochimica et biophysica acta. 1821(6):895-907. 2012.
- Huber N, Guimaraes S, Schrader M, Suter U, Niemann A. Charcot-Marie-Tooth disease-associated mutants of GDAP1 dissociate its roles in peroxisomal and mitochondrial fission. EMBO reports. 14(6):545-52. 2013.
- Krause C, Rosewich H, Woehler A, Gärtner J. Functional analysis of PEX13 mutation in a Zellweger syndrome spectrum patient reveals novel homooligomerization of PEX13 and its role in human peroxisome biogenesis. Human molecular genetics. 22(19):3844-57. 2013.
- Kassmann CM, Quintes S, Rietdorf J. A role for myelin-associated peroxisomes in maintaining paranodal loops and axonal integrity. FEBS letters. 585(14):2205-11. 2011.
- Grønborg S, Krätzner R, Rosewich H, Gärtner J. Lymphoblastoid cell lines for diagnosis of peroxisome biogenesis disorders. JIMD reports. 1:29-36. 2011.
- Cohen Y, Klug YA, Dimitrov L. Peroxisomes are juxtaposed to strategic sites on mitochondria. Molecular bioSystems. 10(7):1742-8. 2014.
Related Products / Services
Please note: All products are "FOR RESEARCH USE ONLY AND ARE NOT INTENDED FOR DIAGNOSTIC OR THERAPEUTIC USE"
